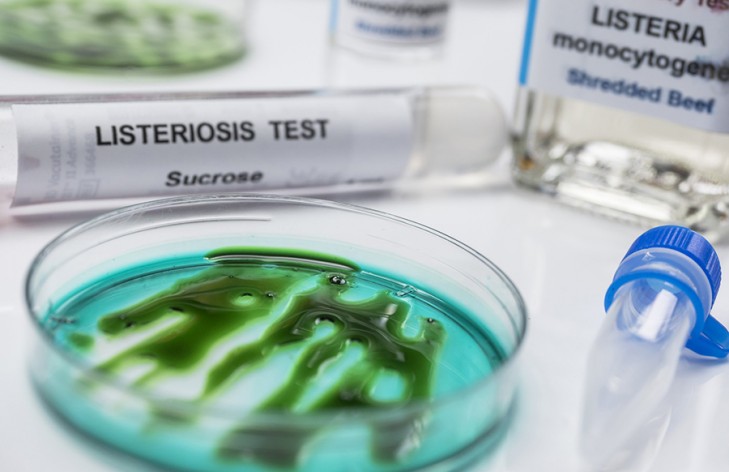

Инвесторы в Минской области больше всего вкладываются в обрабатывающую промышленность. Об этом рассказала заместитель председателя комитета экономики Минского облисполкома Валентина Осадчик.
“Наиболее привлекаемая сфера у инвесторов в Минской области по программе “Один район – один проект” – это обрабатывающая промышленность. Удельный вес составляет 26,1%. Также мы отмечаем жилищное строительство, которое в структуре занимает 26%. Можно отметить сельское, лесное и рыбное хозяйство – это 17,9%. Все остальные отрасли тоже понемногу охватываются”, – сказала Валентина Осадчик.
Инвестируют в региональные проекты как государственные предприятия, так и частный бизнес. Привлекаются и зарубежные инвесторы. “Идет рост прямых иностранных инвестиций”, – подчеркнула она.
БЕЛТА.